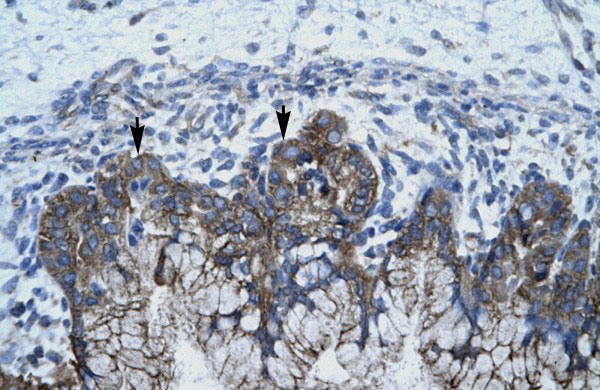

> Antigen, Antibodies, ELISA, Western Blot > Primary Antibody > Polyclonal Antibodies > APOBEC3G antibody - N-terminal regionBrand |
Leading Biology | Catalog Number |
APR10990G |
Product Type |
Polyclonal Antibodies | Field of Research |
|
Product Overview |
We constantly strive to ensure we provide our customers with the best antibodies. As a result of this work we offer this antibody in purified format.
We are in the process of updating our datasheets. If you have any questions regarding this update, please feel free to contact our technical support team.
This product is a high quality APOBEC3G antibody - N-terminal region.
|
||
Molecular Weight |
46 kDa
|
||
Cellular Localization |
Antigen Cellular Localization:
Cytoplasm. Nucleus. Cytoplasm, P-body. Note=Mainly cytoplasmic. Small amount are found in the nucleus During HIV-1 infection, virion-encapsidated in absence of HIV-1 VIF
|
||
Host |
Rabbit
|
||
Species Reactivity |
Human, Pig
|
||
Target |
APOBEC3G is a member of the cytidine deaminase gene family. It is one of seven related genes or pseudogenes found in a cluster, thought to result from gene duplication, on chromosome 22. Members of the cluster encode proteins that are structurally and functionally related to the C to U RNA-editing cytidine deaminase APOBEC1. It is thought that the proteins may be RNA editing enzymes and have roles in growth or cell cycle control. The protein encoded by this gene has been found to be a specific inhibitor of human immunodeficiency virus-1 (HIV-1) infectivity.
|
||
GeneID |
|||
UniProt ID |
|||
Function |
DNA deaminase (cytidine deaminase) which acts as an inhibitor of retrovirus replication and retrotransposon mobility via deaminase-dependent and -independent mechanisms. Exhibits potent antiviral activity against vif-deficient HIV-1. After the penetration of retroviral nucleocapsids into target cells of infection and the initiation of reverse transcription, it can induce the conversion of cytosine to uracil in the minus-sense single-strand viral DNA, leading to G-to-A hypermutations in the subsequent plus-strand viral DNA. The resultant detrimental levels of mutations in the proviral genome, along with a deamination- independent mechanism that works prior to the proviral integration, together exert efficient antiretroviral effects in infected target cells. Selectively targets single-stranded DNA and does not deaminate double-stranded DNA or single-or double- stranded RNA. Exhibits antiviral activity also against simian immunodeficiency viruses (SIVs), hepatitis B virus (HBV), equine infectious anemia virus (EIAV), xenotropic MuLV-related virus (XMRV) and simian foamy virus (SFV). May inhibit the mobility of LTR and non-LTR retrotransposons.
|
||
Summary |
This is a rabbit polyclonal antibody against APOBEC3G. It was validated on Western Blot and immunohistochemistry by Abgent. At Abgent we manufacture rabbit polyclonal antibodies on a large scale (200-1000 products/month) of high throughput manner. Our antibodies are peptide based and protein family oriented. We usually provide antibodies covering each member of a whole protein family of your interest. We also use our best efforts to provide you antibodies recognize various epitopes of a target protein. For availability of antibody needed for your experiment, please inquire (sales@abgent.com).
|
||
Form |
Liquid. Purified antibody supplied in 1x PBS buffer with 0.09% (w/v) sodium azide and 2% sucrose. |
||
Storage & Stability |
Store at +4°C short term. For long-term storage, aliquot and store at -20°C or below. Stable for 12 months at -20°C. Avoid repeated freeze-thaw cycles.
|
||
Applications |
WB, IHC
|
||
Synonyms |
DNA dC->dU-editing enzyme APOBEC-3G, 354-, APOBEC-related cytidine deaminase, APOBEC-related protein, ARCD, APOBEC-related protein 9, ARP-9, CEM-15, CEM15, Deoxycytidine deaminase, A3G, APOBEC3G
|
||
Images |
APOBEC3G antibody - N-terminal region (APR10990G) in Human Stomach cells using Immunohistochemistry Human Stomach 
APOBEC3G antibody - N-terminal region (APR10990G) in Human Daudi cells using Western Blot WB Suggested Anti-APOBEC3G Antibody Titration: 0.2-1 μg/ml ELISA Titer: 1:1562500 Positive Control: Daudi cell lysate |
||
Specification |
|||
Quantity |
|
||
| Select | Brand | Catalog No. | Product Name | Pack Size | Type | Field of Research | Specification | Quantity | Price(USD) | |
| 1 | Leading Biology | APR03440G | ITGA11 Antibody (N-term) | 100 μl | Polyclonal Antibodies |
|
$495.00 | Add Ask | ||
| 2 | Leading Biology | APR04537G | CMIP Antibody (C-term) | 100 μl | Polyclonal Antibodies |
|
$495.00 | Add Ask | ||
| 3 | Leading Biology | APR12422G | Human H4 Histamine Receptor (extracellular) Antibody | 50 μl | Polyclonal Antibodies |
|
$695.00 | Add Ask | ||
| 4 | Leading Biology | APR03844G | UBE2W Antibody (C-term) | 100 μl | Polyclonal Antibodies |
|
$495.00 | Add Ask | ||
| 5 | Leading Biology | APR04349G | HECTD2 Antibody (N-term) | 100 μl | Polyclonal Antibodies |
|
$495.00 | Add Ask | ||
| 6 | Leading Biology | APR03502G | IGHG1 Antibody (Center) | 100 μl | Polyclonal Antibodies |
|
$495.00 | Add Ask |
 Leading Biology Inc.
2600 Hilltop DR, Building G, B Suite C138
Richmond, CA, 94806
Tel: 1-661-524(LBI)-0262
Email: info@leadingbiology.com
Leading Biology Inc.
2600 Hilltop DR, Building G, B Suite C138
Richmond, CA, 94806
Tel: 1-661-524(LBI)-0262
Email: info@leadingbiology.com
Complete this form and click send to ask us a question, request a quote or simply say hello.

You have 0 item in your cart

You have 0 item in your inquiry list
